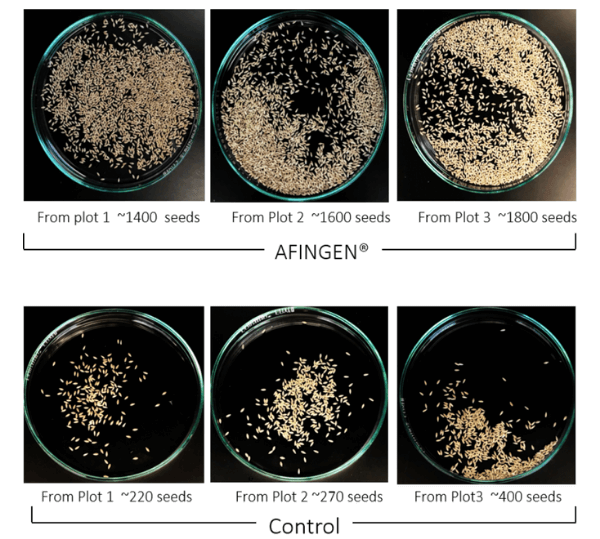

TO GROW
FASTER AND HEALTHIER
We are developing synthetic biology methods to improve crop yield and other beneficial agricultural traits. From a suite of synthetic biology tools, AFINGEN® Positive Feedback Loop (APFL) platform offers a robust path to improve commercially competitive crops with minimal cisgenic/intragenic manipulation and improved genetic stability compared to conventional bioengineering. By the selective amplification and/or reduction of target genes with unprecedented specificity and improved tolerance engineered crops (e.g. rice, corn, wheat, soybeans, canola, alfalfa, and sorghum) may offer higher yields of biomass, more cellulose, and less lignin with healthy and robust plant growth. The increased quantity of higher-quality feedstocks will provide more available nutrient substrates for better animal and human health.
Innovation
AFINGEN® Technology’s Concept

Fast Growth and More Biomass
AFINGEN’s Enabled Trait No. 1

Better Seed/Grain Yield
AFINGEN’s Enabled Trait No. 2

Better Root Development
AFINGEN’s Enabled Trait No. 3

Better Process-ability and Digestability
AFINGEN’s Enabled Trait No. 4
Towards Sustainable Agricultural System
by AFINGEN® Enabled Traits


